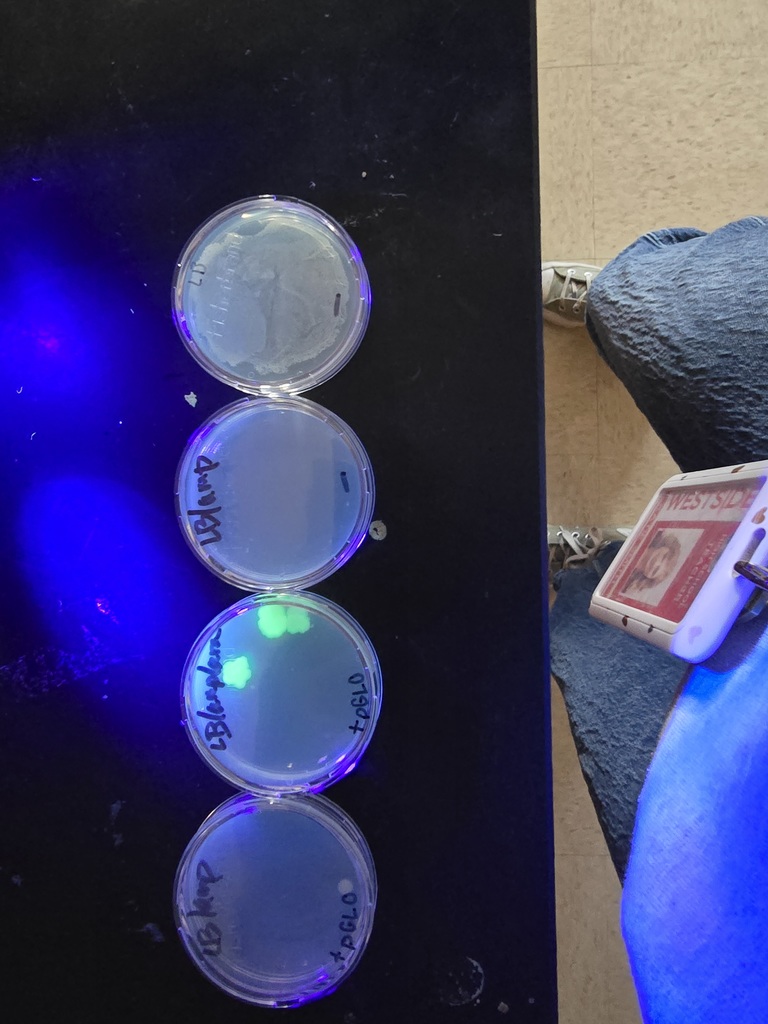
WHS AP Biology students in Ms. Smith’s class recently participated in a biotechnology lab hosted by Dr. Whitney Holden from ASMSA. Students used the pGLO plasmid to genetically modify bacteria, causing it to fluoresce under black light.

Due to a double bus route today, Bus 76 (Racecar) students will ride with Bus 82 (Battleship). Please expect Bus 76 drop-offs to be approximately 20 minutes later than usual.
Ms. Rodgers’ 8th Grade Enhanced Social Studies students recently completed a hands-on project called “Civil War Battle Boxes.”
Each student was assigned a specific Civil War battle and tasked with recreating it in a shoebox diorama. Along with their detailed models, students also created a one-page written summary explaining the key events, strategies, and outcomes of their battle.
Thank you, Mrs. Rodgers, for a creative and engaging way to make history come alive!
Each student was assigned a specific Civil War battle and tasked with recreating it in a shoebox diorama. Along with their detailed models, students also created a one-page written summary explaining the key events, strategies, and outcomes of their battle.
Thank you, Mrs. Rodgers, for a creative and engaging way to make history come alive!





Tonight, we were proud to recognize outstanding WHS students during the school board meeting!
The WHS Educators Rising teams will compete at the State Conference on Thursday at ASU Beebe. Team members Kelsie Cobb, Jaxson Hines, Darcy Ford, and Destinee Tate, along with their teacher Lindsay James, shared information about their upcoming competitions and the work they’ve put in to prepare.
We also recognized the WHS Boys Bowling Team for winning the 4A State Championship! The team will compete in the state finals on Friday, and we wish them the very best as they continue their incredible season.
From future educators to state champion athletes, our Westside Warriors continue to represent our district with excellence and dedication! ❤️🤍
The WHS Educators Rising teams will compete at the State Conference on Thursday at ASU Beebe. Team members Kelsie Cobb, Jaxson Hines, Darcy Ford, and Destinee Tate, along with their teacher Lindsay James, shared information about their upcoming competitions and the work they’ve put in to prepare.
We also recognized the WHS Boys Bowling Team for winning the 4A State Championship! The team will compete in the state finals on Friday, and we wish them the very best as they continue their incredible season.
From future educators to state champion athletes, our Westside Warriors continue to represent our district with excellence and dedication! ❤️🤍


Westside Families — we value your feedback!
Please take a few minutes to complete our Spring 2026 Family & Engagement Survey. Your input helps us continue improving communication, programs, and support for our students.
Thank you for partnering with us to make Westside the best it can be!
https://forms.gle/xtPbP5z9yZfgP9Pm9
Please take a few minutes to complete our Spring 2026 Family & Engagement Survey. Your input helps us continue improving communication, programs, and support for our students.
Thank you for partnering with us to make Westside the best it can be!
https://forms.gle/xtPbP5z9yZfgP9Pm9
The WHS Girls and Boys District Basketball Tournament starts today and brackets are posted below! Check out when our Warriors play and make plans to come cheer them on. Let’s pack the stands, Warriors! ❤️🤍


Mrs. Jarman’s 8th Grade Science students have been busy learning about how the sun’s angle changes throughout the year!
Using flashlights to model sunlight, students observed how the angle of light affects how much energy reaches an area. They measured, calculated, and saw firsthand why sunlight is more intense in some seasons than others.
It’s been a great example of hands-on learning in action at WHS! ❤️🤍
Using flashlights to model sunlight, students observed how the angle of light affects how much energy reaches an area. They measured, calculated, and saw firsthand why sunlight is more intense in some seasons than others.
It’s been a great example of hands-on learning in action at WHS! ❤️🤍


The Westside Jr High Quiz Bowl team finished their season on a high note, finishing 3rd in the State Tournament (Blue Division.)
Sawyer Nix (8th grade) received medals for both All-Conference and All-State, and finished in the top 12 of all competitors in 4A.
Congratulations, Warriors! ❤️🤍
Sawyer Nix (8th grade) received medals for both All-Conference and All-State, and finished in the top 12 of all competitors in 4A.
Congratulations, Warriors! ❤️🤍


Basketball District Tournament Reminder: $5 Admission (adults & students). AAA passes only. No chairback passes. Separate ticket required. WHS Boys vs. Pocahontas tonight at 5:30. Come support our Warriors!
Warrior Week Ahead | February 16–21st
It’s another busy and exciting week for our Warriors! Good luck to our athletes and musicians representing Westside this week! Let’s have a great week, Warriors! ❤️🤍
Feb. 16–21 – GBB/BBB 4A District Basketball Tournament (Hosted at Westside)
Come out and support our teams!
Feb. 16 | 7:00 PM – School Board Meeting
High School Library
Feb. 18–21 – WHS Band All-State Music Clinic
Hot Springs
Feb. 19–21 – WHS Choir All-State Clinic
Hot Springs
It’s another busy and exciting week for our Warriors! Good luck to our athletes and musicians representing Westside this week! Let’s have a great week, Warriors! ❤️🤍
Feb. 16–21 – GBB/BBB 4A District Basketball Tournament (Hosted at Westside)
Come out and support our teams!
Feb. 16 | 7:00 PM – School Board Meeting
High School Library
Feb. 18–21 – WHS Band All-State Music Clinic
Hot Springs
Feb. 19–21 – WHS Choir All-State Clinic
Hot Springs
4A-3 District Basketball Tournament – Hosted at Westside, February 16th-21st!
Westside is proud to host the 4A-3 District Basketball Tournament for both Girls and Boys!
We are excited to welcome teams, players, and fans to our campus for an action-packed tournament. Be sure to check out the attached brackets for game matchups and times. Admission will be $5 (Adults and Students)
Let’s pack the stands in the Warrior Dome as we cheer on some great basketball! ❤️🤍
Westside is proud to host the 4A-3 District Basketball Tournament for both Girls and Boys!
We are excited to welcome teams, players, and fans to our campus for an action-packed tournament. Be sure to check out the attached brackets for game matchups and times. Admission will be $5 (Adults and Students)
Let’s pack the stands in the Warrior Dome as we cheer on some great basketball! ❤️🤍


Parents, please note that we will have a double bus route this afternoon.
Bus #76 (Racecar) students will ride with Bus #79 (Zebra) today. As a result, students who normally ride the Racecar bus will be approximately 20 minutes behind their usual drop-off time.
Thank you for your patience and understanding as we work to get all of our students home safely.
Bus #76 (Racecar) students will ride with Bus #79 (Zebra) today. As a result, students who normally ride the Racecar bus will be approximately 20 minutes behind their usual drop-off time.
Thank you for your patience and understanding as we work to get all of our students home safely.
Registration for 2026–2027 Kindergarten & Pre-K is just around the corner! March 9-11th from 8:30a.m. to 2:30 p.m.
We are excited to welcome a new class of Lil’ Warriors to our school family! ❤️🤍
Be sure to check the attached flyers for details on the documents required at registration. For your convenience, links are provided below for a printable copy of the registration packet. For any questions, call Mrs. Georgie at 870-336-9242.
We can’t wait to meet our newest Warriors and start an amazing school year together! 🥰
Pre-K Enrollment Packet: https://5il.co/3tq2a
Kindergarten Enrollment Packet: https://5il.co/3tq2e
We are excited to welcome a new class of Lil’ Warriors to our school family! ❤️🤍
Be sure to check the attached flyers for details on the documents required at registration. For your convenience, links are provided below for a printable copy of the registration packet. For any questions, call Mrs. Georgie at 870-336-9242.
We can’t wait to meet our newest Warriors and start an amazing school year together! 🥰
Pre-K Enrollment Packet: https://5il.co/3tq2a
Kindergarten Enrollment Packet: https://5il.co/3tq2e
👑✨ 2026 Miss Warrior Pageant ✨👑
We are excited to announce the 2026 Miss Warrior Pageant for students in PreK–12th grade! If your child would like to participate, be sure to submit your entry by February 25th.
How to Register:
• Return registration forms to your child’s school office
OR
• Register online using the QR Code
*This event is proudly sponsored by the WHS Athletic Booster Club.
We are excited to announce the 2026 Miss Warrior Pageant for students in PreK–12th grade! If your child would like to participate, be sure to submit your entry by February 25th.
How to Register:
• Return registration forms to your child’s school office
OR
• Register online using the QR Code
*This event is proudly sponsored by the WHS Athletic Booster Club.



The WHS Boys Bowling Team are 4A State Champions! 👏👏 💪❤️🤍
They will compete in the Overall State Championship next Friday at Hijinx in Jonesboro!
Cole George finished 3rd Overall Individual
All-State Honors: Cole George, Gavin Key, and Corbit Hiser
The Girls Bowling Team also had a fantastic showing, finishing 4th in the state!
All-State: McKyna Craig
Overall State Championship Alternates: McKyna Craig and Mary Dement
Congratulations, Warriors! ❤️



WHS Bowling Senior Night will be held Thursday, February 12th at the Warrior Dome. Parents are asked to arrive by 5:30 p.m., with the ceremony beginning at approximately 5:40 p.m.
WHS AP Biology students in Ms. Smith’s class recently participated in a biotechnology lab hosted by Dr. Whitney Holden from ASMSA. Students used the pGLO plasmid to genetically modify bacteria, causing it to fluoresce under black light.

Jr High Basketball District Tournament Begins Today!
The Jr High girls’ and boys’ district tournament kicks off today at Gosnell High School.
Girls play at 4:00 PM
Boys play at 5:15 PM
Entry fee: $5 for everyone
Good luck to our Warriors! ❤️🤍
The Jr High girls’ and boys’ district tournament kicks off today at Gosnell High School.
Girls play at 4:00 PM
Boys play at 5:15 PM
Entry fee: $5 for everyone
Good luck to our Warriors! ❤️🤍


Westside Schools Nine-Weeks Calendar Note:
Due to recent weather disruptions, we’ve made a small adjustment to our nine-weeks schedule.
The 3rd nine weeks will now end on March 13, and the 4th nine weeks will begin on March 16.
Thank you for your understanding and flexibility.
Due to recent weather disruptions, we’ve made a small adjustment to our nine-weeks schedule.
The 3rd nine weeks will now end on March 13, and the 4th nine weeks will begin on March 16.
Thank you for your understanding and flexibility.
The Bowling State Tournament will be held on Wednesday, February 11th at Fast Lanes in Lowell, Arkansas.
Our Warrior Bowling Teams will be competing, and we wish them the best as they represent Westside on the state level!
Tickets are online only: https://gofan.co/app/school/AAA?activity=Bowling
Good luck and roll strong, Warriors! ❤️🤍
Our Warrior Bowling Teams will be competing, and we wish them the best as they represent Westside on the state level!
Tickets are online only: https://gofan.co/app/school/AAA?activity=Bowling
Good luck and roll strong, Warriors! ❤️🤍


Westside Junior High Quiz Bowl finished 3rd in the Conference Tournament at Clinton on Friday, and now qualify for the Statewide End-of-Season Tournament in Fort Smith on Saturday February 14.
8th Grader Sawyer Nix was selected to the all-tournament team! Way to go Warriors! ❤️🤍



